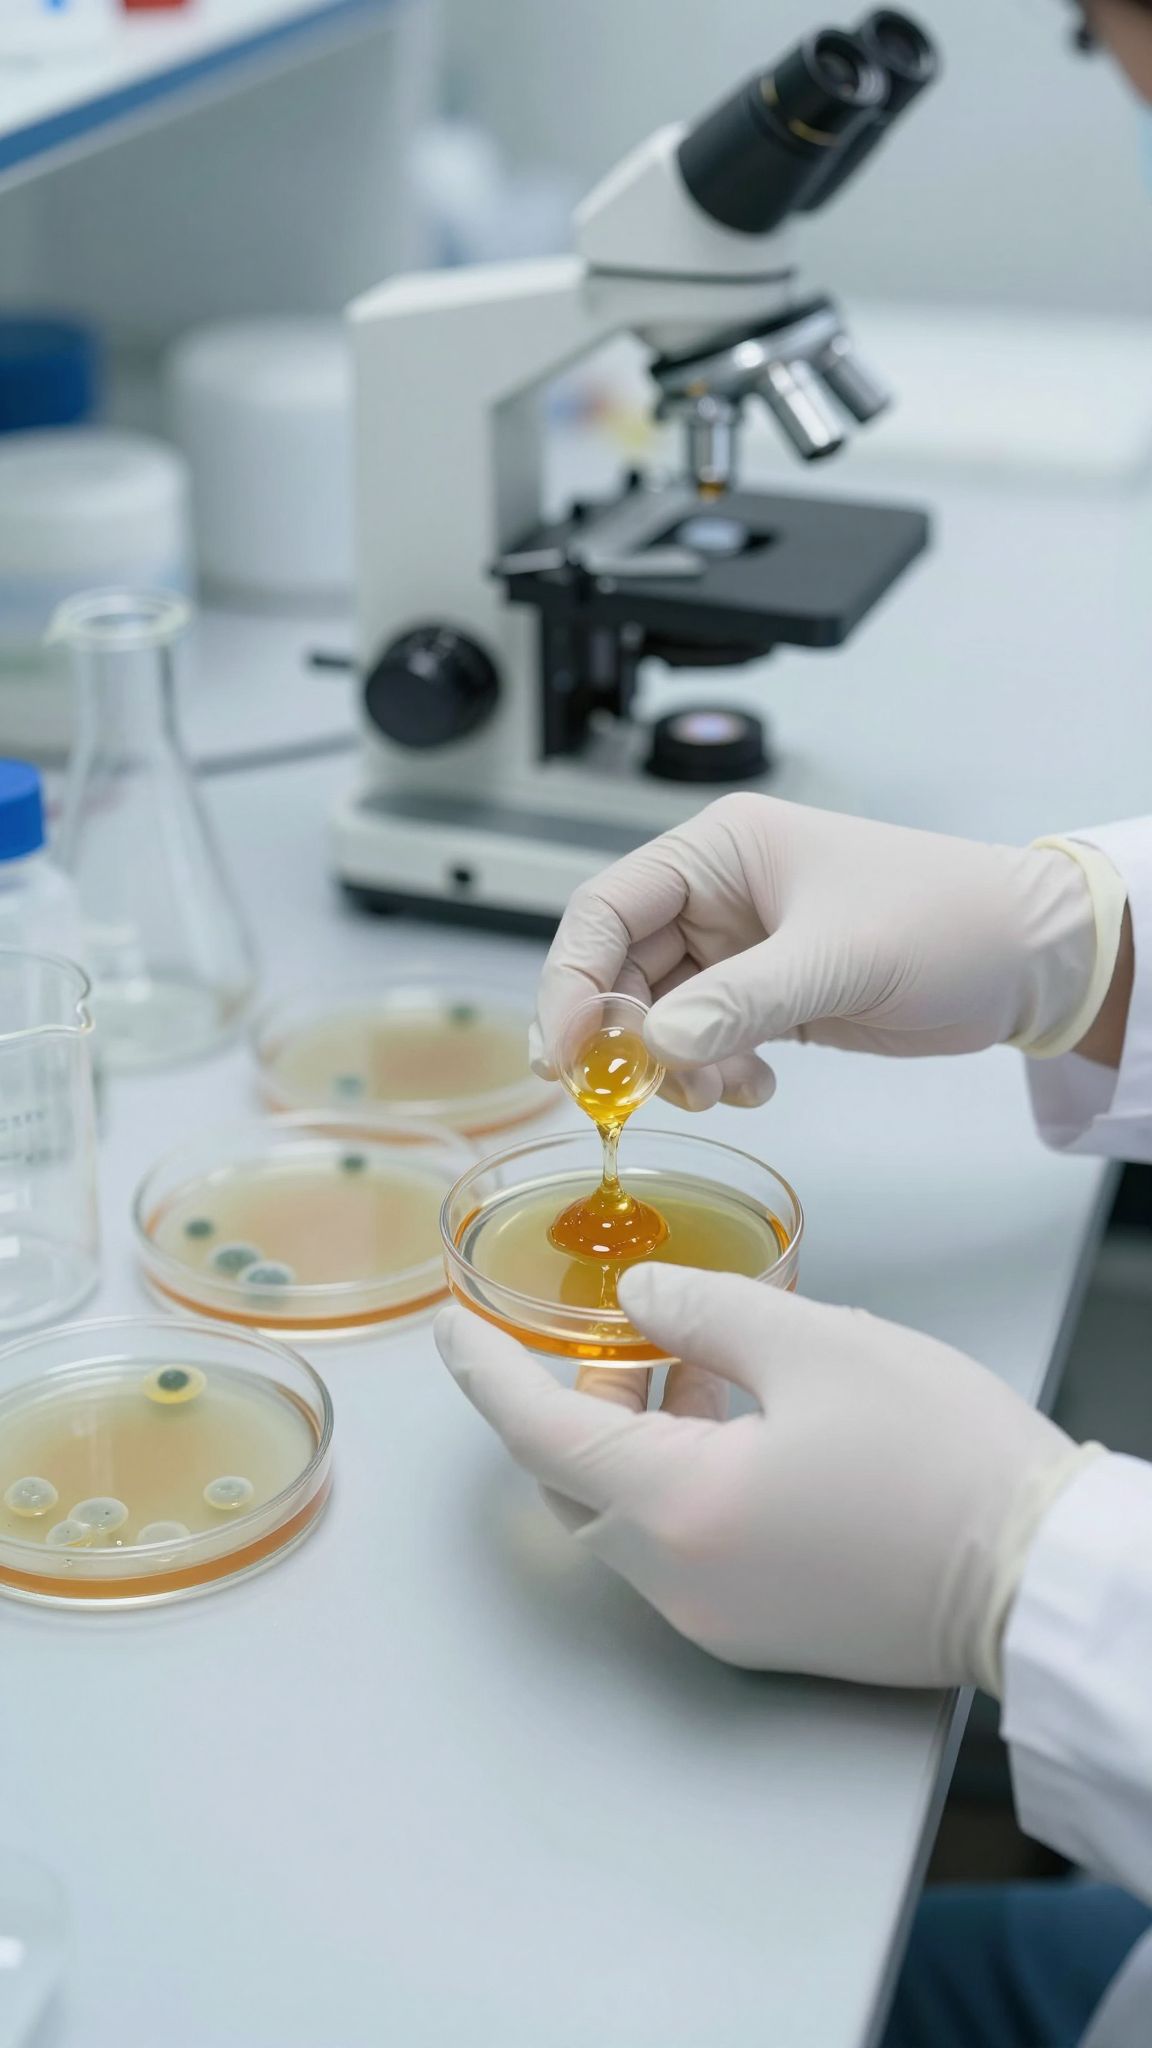
A méz sebkezelésben akut és krónikus fertőzéseket gyógyít.

A méz, e csodálatos természetes édesítőszer, évezredek óta ismert és használt gyógyító tulajdonságairól. Különösen kiemelkedőek antibakteriális képességei, amelyek révén hatékonyan képes felvenni a harcot különféle kórokozókkal szemben. Ez teszi őt a természet egyik legértékesebb antimikrobiális szerévé.
A méz komplex összetétele révén képes gátolni a baktériumok szaporodását és elpusztítani azokat.
Ennek az egyedülálló hatásnak több oka is van. Az egyik legfontosabb tényező a magas cukortartalom, amely ozmotikus hatást fejt ki. Ez azt jelenti, hogy a méz kiszívja a vizet a baktériumsejtekből, így azok nem tudnak életben maradni és szaporodni. Emellett a méz tartalmazza a glükóz-oxidáz enzimet, amely a méhek által termelt, és amely a mézben található glükózt hidrogén-peroxiddá alakítja. A hidrogén-peroxid pedig egy ismert és hatékony fertőtlenítőszer, amely képes elpusztítani a baktériumokat.
Nem szabad megfeledkezni a méz alacsony pH-értékéről sem, ami savas környezetet teremt. Ez a savasság tovább gátolja a baktériumok növekedését, különösen azokat, amelyek optimális körülmények között, semlegesebb pH-n fejlődnek. Ezen kívül, a mézben találhatóak különféle bioaktív vegyületek, mint például a flavonoidok és fenolsavak, amelyeknek szintén van antimikrobiális hatása. Ezek a vegyületek synergikusan hatnak más összetevőkkel, növelve a méz általános fertőtlenítő képességét.
Fontos megérteni, hogy a méz antibakteriális hatékonysága függ a méz típusától. Különböző növények nektárjából készült mézek eltérő mennyiségű és típusú bioaktív vegyületet tartalmazhatnak, így hatékonyságuk is változhat. Például a manukaméz, amely Új-Zélandról és Ausztráliából származik, különösen gazdag az úgynevezett „Unique Manuka Factor” (UMF) nevű vegyületben, amelynek kiemelkedő antibakteriális tulajdonságai vannak, és amely nem származik hidrogén-peroxidból. Ez teszi a manukamézt különösen értékessé sebkezelésben és fertőzések leküzdésében.
A méz alkalmazása nem korlátozódik a belső fogyasztásra. Külsőleg alkalmazva sebgyógyító és fertőzésgátló hatású lehet. Különösen hatékony lehet kisebb sérülések, horzsolások, égési sérülések és fekélyek kezelésében. A méz nedves sebkörnyezetet biztosít, ami segíti a gyógyulási folyamatot, miközben antibakteriális hatásával megelőzi a fertőzéseket.
A méz összetétele és antibakteriális hatásának mechanizmusa
A méz antibakteriális hatásának hátterében számos összetevő és kölcsönhatás áll, melyek együttesen alkotják annak komplex antimikrobiális profilját. Mint az előzőekben említésre került, a magas cukortartalom ozmotikus hatása és az alacsony pH létfontosságúak a baktériumok szaporodásának gátlásában. Ezen túlmenően azonban, a méz gazdag különböző bioaktív vegyületekben, amelyek további mechanizmusokon keresztül járulnak hozzá antibakteriális képességeihez.
Az egyik legfontosabb ilyen vegyületcsoport a flavonoidok és a fenolsavak. Ezek a növényi eredetű antioxidánsok nem csupán a méz színét és ízét befolyásolják, hanem jelentős antimikrobiális tulajdonságokkal is rendelkeznek. Képesek megzavarni a baktériumok sejtfalának integritását, gátolni az enzimrendszereik működését, és csökkenteni a baktériumok által termelt toxinok mennyiségét. Ezek a vegyületek különösen fontosak lehetnek a rezisztens baktériumtörzsekkel szembeni küzdelemben, ahol a hagyományos antibiotikumok hatékonysága csökken.
A glükóz-oxidáz enzim által termelt hidrogén-peroxid mellett, egyes mézek, mint például a már említett manukaméz, nem-peroxidikus antibakteriális komponenseket is tartalmaznak. Ezek közül a legkiemelkedőbb a metilglioxál (MGO), amely nagy koncentrációban található meg a manukamézben. Az MGO képes kovalens kötéseket kialakítani a baktériumok fehérjéivel, ezáltal károsítva azok működését és elpusztítva a sejteket. Ez a mechanizmus független a hidrogén-peroxid termelésétől, így a manukaméz hatékonysága kevésbé függ a méz tárolási körülményeitől vagy hígításától.
A méz antibakteriális hatása egy szinergikus folyamat eredménye, ahol az ozmotikus hatás, a savasság, a hidrogén-peroxid, valamint a különféle bioaktív vegyületek (flavonoidok, fenolsavak, metilglioxál) együttesen fejtik ki hatásukat.
Fontos megérteni, hogy a méz nem csak az általános baktériumokat pusztítja el, hanem bizonyos típusú antibiotikum-rezisztens baktériumokkal szemben is hatékony. Kutatások kimutatták, hogy a méz képes gátolni a Staphylococcus aureus (MRSA), Pseudomonas aeruginosa és Escherichia coli bizonyos törzseinek növekedését. Ez a képessége különösen értékessé teszi a modern orvostudományban, különösen a fertőzések kezelésében és a sebkezelésben.
A mézben található egyéb összetevők, mint például a kis mennyiségű fehérje és aminosavak, szintén hozzájárulhatnak az antimikrobiális hatékonysághoz, bár ezek szerepe kevésbé jelentős, mint a főbb antibakteriális komponenseké. A méz összetétele rendkívül változatos, és függ a méhek által gyűjtött növények fajtájától, a környezeti tényezőktől és a feldolgozási módtól. Ez a komplexitás teszi a mézet egyedülállóvá a természetes antimikrobiális szerek között.
Hidrogén-peroxid termelés a mézben
A méz egyik legfontosabb és legszélesebb körben elismert antibakteriális mechanizmusa a hidrogén-peroxid termelése. Ez a folyamat a mézben található glükóz-oxidáz enzimnek köszönhető, melyet a méhek a nektár gyűjtése során juttatnak a mézbe. Amikor a méz vízhez ér, vagy hígul, ez az enzim reakcióba lép a mézben lévő glükózzal.
A glükóz-oxidáz katalizálja a glükóz oxidációját, melynek során glükonsav és hidrogén-peroxid keletkezik. Ez utóbbi, a H₂O₂, egy ismert és hatékony fertőtlenítőszer. A hidrogén-peroxid képes oxidálni és elpusztítani a baktériumok sejtfalát és belső alkotóelemeit, ezáltal megakadályozva azok szaporodását és életben maradását. A hidrogén-peroxid koncentrációja a mézben általában alacsony, de folyamatosan termelődik, így biztosítva egy tartós antimikrobiális hatást.
A hidrogén-peroxid termelése a mézben egy lassú, enzim által katalizált folyamat, amely kulcsfontosságú a méz antibakteriális hatásában.
Fontos megemlíteni, hogy a hidrogén-peroxid hatása nem minden mézfajtánál egyforma. Vannak olyan mézek, mint például a manukaméz, amelyeknek az antibakteriális hatása nagyrészt más, nem-peroxidikus komponensektől származik. Azonban a legtöbb méz esetében a glükóz-oxidáz által termelt hidrogén-peroxid jelenti az egyik fő antimikrobiális tényezőt. A hidrogén-peroxid termelésére való képesség a méz stabilitását és eltarthatóságát is befolyásolja, segítve megőrizni annak minőségét.
A hidrogén-peroxid hatékonysága függ a méz víztartalmától is. Magasabb víztartalom esetén az enzim aktivitása erőteljesebb, így több hidrogén-peroxid termelődhet. Ugyanakkor a túl magas víztartalom csökkentheti a méz ozmotikus hatását és savasságát, ami szintén hozzájárul az antibakteriális képességéhez. Ezért a méz optimális víztartalma kulcsfontosságú az összes antibakteriális mechanizmus hatékony működéséhez.
A hidrogén-peroxid mellett a mézben jelen lévő flavonoidok és fenolsavak is képesek befolyásolni a baktériumok növekedését, és bizonyos esetekben szinergiában működhetnek a hidrogén-peroxiddal, fokozva annak hatását.
A méz ozmotikus hatása és magas cukortartalma

A méz egyik legmeghatározóbb antibakteriális tulajdonsága az ozmotikus hatás, amelyet elsősorban magas cukortartalma vált ki. Ez a jelenség alapvető a baktériumok túléléséhez és szaporodásához szükséges vízkiszárításában rejlik. A mézben található cukrok, főként a glükóz és a fruktóz, rendkívül koncentráltan vannak jelen, jóval meghaladva a baktériumsejtekben található cukorkoncentrációt. Ez a jelentős koncentrációkülönbség ozmózis révén arra készteti a vizet, hogy a baktériumsejtek belsejéből kifelé, a mézbe áramoljon. Ennek eredményeképpen a baktériumsejtek dehidratálódnak, zsugorodnak, és végső soron nem képesek életben maradni vagy osztódni.
A méz magas cukortartalma révén olyan extrém vízhiányos környezetet teremt, amely a legtöbb baktérium számára elviselhetetlen, gátolva szaporodásukat és túlélésüket.
Az ozmotikus hatás jelentősége abban rejlik, hogy ez egy passzív, fizikai mechanizmus, amely nem igényel aktív enzimatikus vagy kémiai reakciót a méz részéről. Ezáltal a méz még hígított állapotban is képes bizonyos mértékű antibakteriális hatást kifejteni, bár a hatékonyság csökkenhet. A méz összetételében a cukrok aránya általában 80% feletti, ami rendkívül magasnak számít a természetes élelmiszerek között. Ez a koncentráció teszi lehetővé az erős ozmotikus nyomás kialakulását, amely létfontosságú a baktériumok elleni küzdelemben.
Fontos megemlíteni, hogy bár az ozmotikus hatás és a magas cukortartalom az elsődleges mechanizmusok közé tartozik, a méz többi antibakteriális tulajdonsága, mint például az alacsony pH és a bioaktív vegyületek jelenléte, tovább erősíti ezt a hatást. Ezek a tényezők együttesen alkotják a méz komplex antimikrobiális profilját, amely évszázadok óta elismertté tette gyógyászati felhasználását.
A méz alacsony pH-értéke és savassága
A méz egyik kulcsfontosságú antibakteriális tulajdonsága a sajátos savassága. A méz átlagos pH-értéke 3.2 és 4.5 között mozog, ami jelentősen eltér a bőr vagy a vér pH-értékétől, amelyek általában enyhén savasak vagy semlegesek. Ez az alacsony pH-érték létrehoz egy rendkívül kedvezőtlen környezetet a legtöbb baktérium számára, amelyek optimális növekedésükhöz enyhén savas vagy semleges közeget igényelnek.
A savas közeg akadályozza a baktériumok sejtfalának felépítését és működését, valamint befolyásolja az általuk használt enzimek aktivitását. Bizonyos baktériumok, különösen azok, amelyek képesek patogénné válni, nehezen képesek túlélni és szaporodni ilyen savas körülmények között. Ez a tulajdonság, bár már említésre került az előző szakaszokban, önmagában is jelentős mértékben hozzájárul a méz antimikrobiális hatékonyságához, függetlenül más tényezőktől.
A méz alacsony pH-értéke és ebből fakadó savassága alapvető szerepet játszik abban, hogy gátolja a kórokozó mikroorganizmusok, különösen a baktériumok szaporodását.
Érdemes megjegyezni, hogy a méz savassága nem csupán a benne található savaknak (pl. glükonsav) köszönhető, hanem a benne rejlő magas cukortartalomhoz és a hidrogén-peroxid termelődéséhez is szorosan kapcsolódik. Bár a hidrogén-peroxid termelése és az ozmotikus hatás is kiemelkedő, a savas környezet önállóan is egy erőteljes védekezési mechanizmus a baktériumok ellen.
A mézben található egyéb antibakteriális vegyületek
A méz antibakteriális hatását nem csupán a már említett ozmotikus nyomás, savasság és hidrogén-peroxid biztosítja. Számos más, kisebb mennyiségben jelenlévő, de annál jelentősebb hatású vegyület is hozzájárul ehhez az egyedülálló tulajdonsághoz. Ezek a bioaktív komponensek további, specifikus mechanizmusokon keresztül támadják a baktériumokat, gyakran olyan módon, amely a hagyományos antibiotikumokkal szemben is hatékony.
Az egyik ilyen kulcsfontosságú vegyületcsoport a fenolos vegyületek, mint például a kávésav, a ferulasav és az etil-kávésav. Ezek az antioxidánsok nemcsak a méz stabilitását segítik elő, hanem képesek megzavarni a baktériumok sejtfalának szerkezetét, gátolva ezzel a létfontosságú tápanyagok felvételét és a salakanyagok eltávolítását. Ezenkívül szerepet játszanak a baktériumok által termelt biofilmek kialakulásának megelőzésében. A biofilmek baktériumok által létrehozott védőrétegek, amelyek jelentősen megnehezítik az antibiotikumok és az immunrendszer behatolását, így a méz ezen a fronton is segítséget nyújt.
A flavonoidok, mint például a kvercetin és a kaempferol, szintén fontos szerepet töltenek be. Ezek a vegyületek képesek gátolni a baktériumok enzimrendszereinek működését, amelyek létfontosságúak az anyagcseréjük szempontjából. Ezen flavonoidok antimikrobiális hatása gyakran szinergiában érvényesül a méz egyéb összetevőivel, erősítve annak általános fertőtlenítő képességét. Egyes kutatások arra utalnak, hogy a flavonoidok képesek megakadályozni a baktériumok közötti kommunikációt is, ami csökkenti azok virulenciáját.
Külön említést érdemelnek a peptid jellegű vegyületek, amelyek szintén kimutathatók a mézben. Ezek a kisebb fehérjemolekulák, mint például a defenzinek és a lysostaphin, képesek közvetlenül károsítani a baktériumok sejtfalát, különösen a Gram-pozitív baktériumok esetében. Hatásmechanizmusuk gyakran a sejthártya áteresztőképességének növelése, ami a sejt tartalmának kiszivárgásához és végül a baktérium elpusztulásához vezet.
A mézben található, nem-peroxidikus antibakteriális komponensek, mint például a metilglioxál (MGO) és a bizonyos fenolos vegyületek, különösen hatékonyak lehetnek az antibiotikum-rezisztens baktériumtörzsekkel szemben, mivel eltérő mechanizmusokon keresztül hatnak, mint a hagyományos antibiotikumok.
A méz egyéb összetevői, mint a kis mennyiségű szerves savak (pl. ecetsav, hangyasav) és bizonyos ásványi anyagok is finoman módosíthatják a méz antimikrobiális környezetét, hozzájárulva annak komplex hatásához. Ezek az összetevők, bár önmagukban nem rendelkeznek erőteljes antibakteriális hatással, a méz komplex mátrixában együttműködve fokozzák a méz általános képességét a kórokozók elleni küzdelemben.
Flavonoidok és fenolsavak antimikrobiális szerepe
A mézben található flavonoidok és fenolsavak nem csupán a méz jellegzetes színét és ízét adják, hanem kulcsszerepet játszanak antimikrobiális hatásában is. Ezek a növényi eredetű vegyületek, melyek az antioxidánsok csoportjába tartoznak, számos mechanizmus révén képesek gátolni a kórokozó mikroorganizmusok szaporodását és életképességét.
Ezek a bioaktív molekulák képesek megzavarni a baktériumok sejtfalának felépítését, ami gyengíti azok szerkezetét és növeli a sejtek átjárhatóságát. Emellett befolyásolják a baktériumok létfontosságú enzimrendszereinek működését, megakadályozva ezzel az anyagcsere-folyamataikat. Egyes kutatások arra is rámutatnak, hogy a flavonoidok és fenolsavak csökkenthetik a baktériumok által termelt káros toxinok mennyiségét, így mérsékelve a szervezetükre gyakorolt negatív hatást.
A flavonoidok és fenolsavak különösen fontosak lehetnek a modern orvoslásban, mivel hatékonyan léphetnek fel a hagyományos antibiotikumokkal szemben ellenállóvá vált baktériumtörzsekkel szemben is.
A mézben megtalálható flavonoidok és fenolsavak szinergikus hatást fejtenek ki más antimikrobiális komponensekkel, mint például a hidrogén-peroxiddal vagy az ozmotikus hatással. Ez a komplex kölcsönhatás teszi a mézet egyedülálló és rendkívül hatékony természetes antimikrobiális szerévé. A különböző növények nektárjából származó mézek eltérő arányban tartalmazhatnak e vegyületekből, ami magyarázza a mézek között tapasztalható különbségeket az antibakteriális hatékonyság terén.
Példaként említhető a propolisz, amelynek hatékonyságát nagyrészt a benne található flavonoidok és fenolsavak adják. Bár a propolisz nem méz, szorosan kapcsolódik hozzá, és hasonló bioaktív vegyületeket tartalmaz, melyek bizonyítottan erős antimikrobiális tulajdonságokkal bírnak.
Enzimek és peptidek a mézben

A méz antibakteriális hatásának megértéséhez elengedhetetlen az enzimek és peptid molekulák szerepének feltárása. Ezek a biológiailag aktív vegyületek, bár kisebb mennyiségben vannak jelen, mint a cukrok vagy a víz, jelentősen hozzájárulnak a méz antimikrobiális képességeihez. Az egyik legfontosabb enzim a már említett glükóz-oxidáz, amely a méz és a méhek nyálmirigyeinek találkozásakor lép működésbe. Ez az enzim a glükózt glükonsavvá és hidrogén-peroxiddá alakítja. A hidrogén-peroxid, mint ismert fertőtlenítőszer, képes elpusztítani a baktériumokat, különösen az oxigén jelenlétében.
A mézben található defenzinek és apamin nevű peptidek is kiemelkedő szerepet játszanak. Ezeket a méhek termelik, és a mézbe kerülve antimikrobiális aktivitást fejtenek ki. A defenzinek például a baktériumok sejtfalát támadják meg, lyukakat képezve benne, ami a sejt tartalmának kiszivárgásához és a baktérium elpusztulásához vezet. Az apamin pedig idegsejteket befolyásoló hatása révén is hozzájárulhat a kórokozók elleni küzdelemhez, bár ez utóbbi hatásmechanizmus még kutatás tárgya.
Ezen enzimek és peptidek együttesen, a méz más összetevőivel szinergiában, erősítik a méz természetes antibakteriális potenciálját, különösen a manukamézhez hasonló, magasabb bioaktív vegyület tartalmú fajták esetében.
Ezek a molekulák különösen fontosak lehetnek a nem-peroxidikus antibakteriális hatás szempontjából. Míg a hidrogén-peroxid hatékonysága csökkenhet bizonyos körülmények között (pl. hő vagy fény), a peptidek antimikrobiális tulajdonságai stabilabbnak bizonyulnak. Ez magyarázza, miért képes a méz továbbra is hatékonyan fellépni a baktériumok ellen, még akkor is, ha a hidrogén-peroxid koncentrációja csökken. A peptidek képesek gátolni a baktériumok növekedését, megakadályozni a biofilm képződését, és akár a baktériumok által termelt toxikus anyagokat is semlegesíteni.
Különböző mézfajták antibakteriális hatékonyságának összehasonlítása
Bár a méz általános antibakteriális tulajdonságai ismertek, mint az előző részekben tárgyaltuk (ozmotikus hatás, alacsony pH, hidrogén-peroxid és bioaktív vegyületek jelenléte), ezen tulajdonságok mértéke és specifikus hatékonysága jelentősen eltérhet a különböző mézfajták között. Ez a különbség alapvetően a méhek által gyűjtött növények nektárjának összetételéből, valamint a méz feldolgozása és tárolása során bekövetkező változásokból ered.
A manukaméz, amely az ausztrál és új-zélandi manuka cserje (Leptospermum scoparium) virágainak nektárjából készül, az egyik legismertebb és legvizsgáltabb mézfajta antibakteriális hatékonyságát tekintve. Ennek oka a benne található metilglioxál (MGO) magas koncentrációja. Az MGO egy olyan vegyület, amely erőteljes antibakteriális hatással bír, és nem a hidrogén-peroxid révén fejti ki hatását. Emiatt a manukaméz stabilabb és erősebb antimikrobiális hatást mutat, mint más, főként hidrogén-peroxidra támaszkodó mézek. Az MGO tartalom mérésére szolgáló UMF (Unique Manuka Factor) vagy MGO skála jelzi a méz antibakteriális potenciálját.
Más mézfajták, mint például a tölgyfaméz vagy a fenyőméz, amelyek mézharmatból (levéltetvek által kiválasztott cukortartalmú folyadék) készülnek, nem a virágnektárból, gyakran magasabb az antioxidáns tartalmuk és bizonyos ásványi anyagok koncentrációja. Bár ezek is rendelkeznek antibakteriális tulajdonságokkal, hatékonyságuk eltérhet a virágmézekétől. Például a tölgyfamézről kimutatták, hogy erős antioxidáns és gyulladáscsökkentő hatással is bír, amely kiegészíti antimikrobiális képességeit.
A fakó méz, más néven akácméz, ismert finom ízéről és világos színéről. Bár alacsony a hidrogén-peroxid tartalma, ozmotikus hatása és savassága révén mégis hatékonyan gátolja a baktériumok szaporodását. Azonban kevésbé kimagasló az antibakteriális hatékonysága a manukamézhez vagy más, specifikus bioaktív vegyületekben gazdag mézekhez képest.
A napraforgóméz, melynek magas a glükóz-oxidáz enzim tartalma, így jelentős hidrogén-peroxid termelésre képes, ami erőteljes antibakteriális hatást biztosít. A napraforgóméz különösen hatékony lehet a sebkezelésben a fertőzések megelőzése és a gyógyulás elősegítése szempontjából.
Fontos megérteni, hogy a méz antibakteriális hatékonyságának összehasonlítása nem mindig egyszerű. Számos kutatás vizsgálja a különböző mézfajták hatását specifikus baktériumtörzsekre, és az eredmények változatos képet mutatnak. Általánosságban elmondható, hogy a magas MGO tartalmú mézek (mint a manukaméz) és a magas glükóz-oxidáz tartalmú mézek (mint a napraforgóméz) mutatják a legerősebb és legszélesebb spektrumú antibakteriális hatást.
A méz antibakteriális hatékonysága nagymértékben függ a méz típusától, különösen az olyan specifikus vegyületek, mint a metilglioxál (MGO) vagy a glükóz-oxidáz enzim jelenlététől és koncentrációjától.
A méz tárolása és feldolgozása is befolyásolhatja antibakteriális tulajdonságait. A hosszú ideig tartó, magas hőmérsékleten történő tárolás csökkentheti a hidrogén-peroxid képződését és lebomolhatnak bizonyos bioaktív vegyületek, ezáltal gyengítve a méz antimikrobiális hatását. Ezzel szemben a megfelelő tárolás (hűvös, sötét helyen) segít megőrizni a méz értékét.
Manuka méz és specifikus antibakteriális hatása
A manukaméz kiemelkedő helyet foglal el a mézek antibakteriális hatású képviselői között, köszönhetően egyedi összetételének. Míg más mézekben az antibakteriális hatás elsősorban az ozmotikus nyomásból, a hidrogén-peroxidból és a savas pH-ból adódik, a manukaméz esetében egy további, nagyon erős hatóanyag dominál. Ez a metilglioxál (MGO), amely a manukamézben kimagasló koncentrációban található meg. Ez a vegyület felelős a manukaméz jellegzetes, nem-peroxidikus antibakteriális hatásáért, amely független a hidrogén-peroxid jelenlététől.
Az MGO hatásmechanizmusa abban rejlik, hogy képes irreverzibilis kémiai kötéseket létesíteni a baktériumok sejtfalában és a létfontosságú fehérjékben. Ez a folyamat közvetlenül károsítja a baktériumok sejtszerkezetét és működését, végső soron pusztulásukat okozva. Ezen mechanizmus révén a manukaméz hatékony a széles spektrumú baktériumok ellen, beleértve olyanokat is, amelyek más mézekkel szemben ellenállónak bizonyulnának. A Unique Manuka Factor (UMF), melyet gyakran feltüntetnek a manukaméz csomagolásán, egy szabványosított mérőszám, amely a metilglioxál és más, antibakteriális hatású vegyületek együttes koncentrációját jelzi, így segítve a fogyasztókat a minőségi termék kiválasztásában.
A manukaméz metilglioxál (MGO) tartalma teszi lehetővé, hogy rendkívül hatékony legyen a baktériumok széles köre ellen, beleértve azokat is, amelyek ellenállóak lehetnek más mézekkel vagy akár bizonyos antibiotikumokkal szemben is.
A metilglioxál mellett a manukaméz más, kevésbé ismert, de szintén antimikrobiális hatású vegyületeket is tartalmaz, amelyek szinergiában erősítik egymás hatását. Ezek a fenolsavak és flavonoidok, amelyek már korábban említésre kerültek, de a manukamézben található specifikus arányuk és típusuk tovább növeli annak antibakteriális potenciálját. A manukaméz alkalmazása különösen előnyös lehet a fertőzött sebek kezelésében, ahol a baktériumok jelenléte akadályozza a gyógyulást. Az MGO képes mélyen behatolni a sebkörnyezetbe, és ott fejteni ki hatását, míg a méz általános hidratáló és gyulladáscsökkentő tulajdonságai is segítik a regenerációt.
Fontos megemlíteni, hogy a manukaméz antibakteriális hatékonysága nem csökken jelentősen hígítás esetén sem, ellentétben a hidrogén-peroxid alapú hatással bíró mézekkel. Ez a tulajdonsága teszi alkalmassá belsőleg és külsőleg történő alkalmazásra egyaránt, legyen szó akár emésztőrendszeri problémák kezeléséről, akár a bőr fertőzéseinek enyhítéséről. Az MGO magas koncentrációja teszi a manukamézt egyedülállóvá a természetes antimikrobiális szerek palettáján.
A méz hatása különböző baktériumtörzsekre
A méz hatékonysága nem csupán általános baktériumellenes tulajdonságokban nyilvánul meg, hanem képes specifikus és gyakran problémás baktériumtörzsekkel szemben is fellépni. Számos kutatás bizonyította, hogy a méz képes gátolni az Staphylococcus aureus, beleértve a meticillin-rezisztens Staphylococcus aureus (MRSA) törzseket is, amelyek komoly egészségügyi kihívást jelentenek a kórházakban. Az MRSA fertőzések kezelése különösen nehéz lehet a megnövekedett antibiotikum-rezisztencia miatt, így a méz természetes alternatívaként vagy kiegészítő terápiaként jöhet szóba.
Emellett a méz hatékony a gram-negatív baktériumok ellen is. A Pseudomonas aeruginosa, egy gyakori opportunista kórokozó, amely különösen a legyengült immunrendszerű vagy krónikus sebes betegeknél okozhat súlyos fertőzéseket, szintén érzékeny a méz antimikrobiális hatására. Hasonlóképpen, az Escherichia coli (E. coli) bizonyos patogén törzsei is gátolhatók mézzel, ami releváns lehet húgyúti fertőzések vagy emésztőrendszeri problémák esetén.
A méz különböző baktériumtörzsekre gyakorolt hatása összetett, és magában foglalja a baktériumsejtek károsítását, a szaporodásuk gátlását és a biofilm képződésének megakadályozását.
A méz antibakteriális hatása abban is megnyilvánul, hogy képes gátolni a baktériumok biofilm képződését. A biofilm olyan baktériumkolóniákból álló, ragacsos réteg, amely védi a baktériumokat az immunrendszertől és az antibiotikumoktól, megnehezítve a fertőzések leküzdését. A méz összetevői, például a metilglioxál, képesek megzavarni a biofilm kialakulásának folyamatát, ezáltal növelve a szervezet vagy a gyógyszerek hatékonyságát a fertőzésekkel szemben.
A méz hatékonysága a baktériumtörzsekkel szemben méz típusától függően változhat. Például a manukaméz, magas metilglioxál tartalmának köszönhetően, gyakran kimagaslóan hatékony a különböző baktériumtörzsek ellen. Más típusú mézek, mint a repceméz vagy az akácméz, eltérő arányban tartalmazhatnak aktív vegyületeket, így antibakteriális profiljuk is eltérő lehet. Ezért a specifikus alkalmazásokhoz érdemes lehet az adott méz típusának antimikrobiális tulajdonságait figyelembe venni.
A méz széles spektrumú antibakteriális hatása révén, amely kiterjed mind a gram-pozitív, mind a gram-negatív baktériumokra, beleértve az antibiotikum-rezisztens törzseket is, értékes természetes eszközként szolgálhat a fertőzések megelőzésében és kezelésében. Ezen hatások megértése kulcsfontosságú a méz potenciáljának teljes kiaknázásához.
Gram-pozitív és Gram-negatív baktériumok elleni küzdelem
A méz képes hatékonyan felvenni a harcot mind a Gram-pozitív, mind a Gram-negatív baktériumok ellen, bár a hatásmechanizmusok kissé eltérhetnek a baktériumok sejtfalszerkezetéből adódóan. A korábban már említett mechanizmusok, mint az ozmotikus hatás és az alacsony pH, univerzálisan érvényesülnek mindkét baktériumtípus esetében, megnehezítve vagy lehetetlenné téve számukra a túlélést és szaporodást.
A Gram-pozitív baktériumok, mint például a Staphylococcus aureus, vastag peptidoglikán sejtfalukkal rendelkeznek. A méz ozmotikus ereje kiszívja a vizet ezekből a sejtekből, ami sejtfal összeomláshoz és elhaláshoz vezet. Emellett a mézben található hidrogén-peroxid és bioaktív vegyületek, mint a fenolsavak, tovább károsítják a sejtfalat és gátolják az anyagcsere folyamatokat.
A Gram-negatív baktériumok, mint az Escherichia coli vagy a Pseudomonas aeruginosa, vékonyabb peptidoglikán réteggel és egy külső membránnal rendelkeznek. A méz hatása itt is többrétegű. Az ozmotikus hatás és a savasság továbbra is kulcsfontosságú. Azonban a mézben található bizonyos komponensek, különösen a manukamézben található metilglioxál (MGO), képesek áthatolni a külső membránon és a sejtfalon keresztül, közvetlenül károsítva a baktérium belső szerkezetét és létfontosságú fehérjéit.
A méz komplex összetétele révén képes megzavarni mind a Gram-pozitív, mind a Gram-negatív baktériumok sejtfalának integritását és létfontosságú működését.
Különösen figyelemre méltó a méz hatása az antibiotikum-rezisztens törzsekkel szemben. Tanulmányok kimutatták, hogy a méz képes gátolni a meticillin-rezisztens Staphylococcus aureus (MRSA) és bizonyos multirezisztens Pseudomonas aeruginosa törzsek szaporodását, amelyek komoly kihívást jelentenek a modern orvosi gyakorlatban. Ez a képesség a méz bioaktív vegyületeinek, mint a flavonoidok és az MGO, szinergikus hatásának köszönhető.
A méz antibakteriális hatékonyságát befolyásolhatja a baktériumok által termelt biofilm képződésének képessége. A biofilm egy védőréteg, amely megvédi a baktériumokat az immunrendszer és az antibiotikumok támadásaitól. A méz bizonyos eseteiben képes megakadályozni a biofilm kialakulását, vagy akár lebontani a már meglévő biofilmet, ezáltal közvetve hozzájárulva a fertőzés elleni küzdelemhez.
A méz hatása rezisztens baktériumtörzsekre (MRSA)
A méz különösen figyelemre méltó képessége, hogy hatékonyan lép fel a gyógyszerrezisztens baktériumtörzsekkel szemben, beleértve a rettegett methicillin-rezisztens Staphylococcus aureus (MRSA) törzset is. Míg a hagyományos antibiotikumok hatékonysága bizonyos baktériumoknál csökken, a méz antimikrobiális mechanizmusainak összetettsége lehetővé teszi, hogy továbbra is jelentős hatást gyakoroljon.
Az MRSA, amely kórházi fertőzések egyik fő okozója, rendkívül ellenálló a legtöbb elérhető antibiotikummal szemben. A méz azonban képes megtörni ezt az ellenállást. Kutatások kimutatták, hogy a mézben található metilglioxál (MGO), különösen a manukamézben, képes megakadályozni az MRSA sejtfalának kialakulását, valamint gátolni a baktériumok által termelt toxinok hatását. Ez a kettős hatás jelentősen hozzájárul az MRSA-fertőzések leküzdéséhez.
A méz nem csupán elpusztítja a baktériumokat, hanem képes megakadályozni a biofilm képződését is, amely védi a baktériumokat az immunrendszer és az antibiotikumok támadásaitól.
Az ozmotikus hatás és a hidrogén-peroxid mellett, a mézben található flavonoidok és fenolsavak is kulcsszerepet játszanak az MRSA elleni küzdelemben. Ezek a vegyületek képesek kiszárítani a baktériumsejteket és károsítani a sejtmembránt, ezáltal tovább gyengítve az ellenálló törzseket. Az MGO-val és más bioaktív komponensekkel való szinergikus hatásuk révén a méz egyedülálló alternatívát kínál a hagyományos fertőtlenítőszerekkel szemben.
A méz alkalmazása sebeken, különösen azokon, amelyek MRSA-val fertőződtek, nemcsak a baktériumok számának csökkentését segíti elő, hanem gyorsítja a sebgyógyulási folyamatot is. A méz gyulladáscsökkentő tulajdonságai és a nedves sebkörnyezet fenntartása tovább támogatja a szövetek regenerálódását, miközben aktívan küzd a rezisztens kórokozók ellen.
A méz antibakteriális hatásának kutatása és bizonyítékai
A méz antibakteriális hatásának kutatása már évszázadok óta tart, és a modern tudomány egyre több bizonyítékkal támasztja alá a népi gyógyászatban betöltött szerepét. Számos in vitro és in vivo vizsgálat igazolta a méz képességét különféle patogén mikroorganizmusok, köztük baktériumok és gombák elpusztítására vagy növekedésük gátlására. Ezek a kutatások nem csak a méz általános antimikrobiális hatását vizsgálják, hanem igyekeznek feltárni az egyes komponensek specifikus hatásmechanizmusait is.
A kutatók számos mézfajtát elemeztek, hogy megértsék, hogyan befolyásolja a növényi eredet és a feldolgozási módszer az antibakteriális hatékonyságot. Különös figyelmet kapott a manukaméz, amelynek kiemelkedő hatékonyságát a metilglioxál (MGO) tartalma magyarázza. A manukamézben található MGO mennyiségét szabványosították is, így az UMF (Unique Manuka Factor) és az MGO minősítések segítenek azonosítani a magas antibakteriális potenciállal rendelkező termékeket.
A tudományos kutatások egyre inkább megerősítik, hogy a méz nem csupán egy ízletes édesítőszer, hanem hatékony természetes gyógymód is lehet különféle fertőzésekkel szemben.
A klinikai vizsgálatok szintén ígéretes eredményeket mutatnak. Különböző típusú sebek, mint például égési sérülések, diabéteszes lábfekélyek vagy decubitus fekélyek kezelésében a méz alkalmazása gyakran gyorsabb gyógyulást, csökkent fájdalmat és kevesebb fertőzést eredményezett a hagyományos kötszerekhez képest. Az egyik legfontosabb előnye a méznek a sebkezelésben a széles spektrumú antibakteriális hatása, amely kiterjed olyan rezisztens törzsekre is, mint az MRSA (meticillin-rezisztens Staphylococcus aureus).
A méz antibakteriális hatásának kutatása azonban nem áll meg a baktériumoknál. Vizsgálják a gombák elleni hatékonyságát is, és kimutatták, hogy bizonyos mézfajták képesek gátolni a Candida albicans, egy gyakori humán patogén gomba növekedését. Ez tovább bővíti a méz potenciális felhasználási területeit az egészségügyben.
A kutatások fontos célja az is, hogy megértsék, hogyan lehet a mézet integrálni a modern orvosi gyakorlatba, különösen az antibiotikum-rezisztencia növekvő problémájával szemben. A méz természetes eredete és alacsony mellékhatásprofilja vonzó alternatívát kínál a szintetikus gyógyszerekkel szemben, bár a használatát mindig szakember felügyelete mellett javasolják.
In vitro és in vivo vizsgálatok
A méz antibakteriális hatékonyságának alátámasztására számos tudományos kutatás irányult, melyek során in vitro és in vivo vizsgálatok egyaránt zajlottak. Az in vitro (laboratóriumi körülmények között végzett) vizsgálatok során a méz közvetlenül, különböző baktériumtörzsekkel érintkezve mutatott hatékonyságot. Ezek a kísérletek kimutatták, hogy a méz képes gátolni a gram-pozitív és gram-negatív baktériumok növekedését egyaránt, beleértve a patogén törzseket is.
Az in vitro vizsgálatok különösen fontosak a méz különböző komponenseinek és azok hatásmechanizmusainak feltárásában. Például, megfigyelték, hogy a méz különböző hígítási fokozatai eltérő mértékben gátolják a baktériumok szaporodását. A korábban említett ozmotikus hatás és a hidrogén-peroxid termelés mellett, az in vitro kísérletek rávilágítottak a mézben található fenolos vegyületek és flavonoidok antimikrobiális szerepére is. Ezek a vegyületek önmagukban is képesek gátolni a baktériumok sejtfalának képződését és az anyagcsere-folyamataikat.
Az in vitro és in vivo vizsgálatok együttesen bizonyítják a méz széles spektrumú antibakteriális hatékonyságát, ami megalapozza terápiás alkalmazását.
Az in vivo vizsgálatok (élő szervezetben, vagy annak modelljein végzett kísérletek) pedig azt demonstrálják, hogy a méz hatékonyan alkalmazható a gyakorlatban is. Különösen a sebkezelés terén hozott áttörést a méz használata. Például, égési sérülések és krónikus fekélyek kezelésében a mézzel fedett sebek gyorsabban gyógyultak, és a fertőződés kockázata is csökkent a hagyományos kötszerekhez képest. Ezek a klinikai vizsgálatok megerősítették a méz gyulladáscsökkentő és antibakteriális tulajdonságait a biológiai környezetben is.
Az in vivo kutatások során figyelembe vették a méz alkalmazásának módját is. A lokálisan alkalmazott méz (például gélek vagy kenőcsök formájában) közvetlenül a fertőzött területen fejti ki hatását, míg belsőleg fogyasztva az emésztőrendszerben, vagy a véráram útján fejt ki jótékony hatást. Különösen érdekesek azok a kutatások, amelyek a méz hatását vizsgálták a bakteriális biofilm képződésre. A biofilm egy olyan baktériumkolónia, amely egy védő mátrixban él, és rendkívül ellenálló az antibiotikumokkal szemben. A méz képes megakadályozni a biofilm kialakulását és lebontani a már meglévőket, ami kulcsfontosságú a krónikus fertőzések kezelésében.
A különböző mézfajták, mint például a manukaméz, különösen sok kutatás tárgyát képezik. Az in vitro és in vivo vizsgálatok egyaránt kiemelték a manukaméz metilglioxál (MGO) tartalmának jelentőségét, amely erősebb és stabilabb antibakteriális hatást biztosít, mint a hidrogén-peroxid. Ezek a kutatások segítik a méz pontosabb és célzottabb terápiás felhasználását.
Klinikai alkalmazások és tanulmányok
A méz sebkezelésben gyorsítja a gyógyulást és csökkenti a fertőzések kialakulásának esélyét.
A méz antibakteriális tulajdonságait számos klinikai alkalmazás támasztja alá, amelyek a hagyományos orvoslás kiegészítőjeként, illetve alternatívájaként is szerepet kapnak. A kutatások és tapasztalatok egyre inkább megerősítik a méz potenciálját különféle fertőzések kezelésében.
Kiemelt terület a sebkezelés. Számos tanulmány vizsgálta a méz hatékonyságát krónikus sebek, így például diabéteszes lábszárfekélyek, felfekvések és égési sérülések gyógyításában. A méz nemcsak a seb tisztán tartásában és a gyulladás csökkentésében segít, hanem elősegíti a szövetregenerációt is. Ennek oka a már említett komplex összetétel, amely magában foglalja a baktériumok elleni küzdelmet, a gyulladáscsökkentést és a sejtnövekedést stimuláló faktorokat.
A méz különösen ígéretesnek bizonyul a bakteriális fertőzések elleni küzdelemben, beleértve azokat is, amelyek antibiotikum-rezisztens törzsek okoznak. Különböző in vitro és in vivo vizsgálatok kimutatták, hogy a méz képes gátolni a Staphylococcus aureus (beleértve az MRSA törzseket), a Pseudomonas aeruginosa és az Escherichia coli bizonyos törzseinek növekedését. Ez a hatás különösen fontos a kórházi fertőzések visszaszorításában.
A méz, különösen a gyógyászati célra minősített típusai, hatékony eszközként szolgálhat a különféle fertőzések kezelésében, csökkentve az antibiotikum-rezisztencia kialakulásának kockázatát.
Az orrmelléküreg-gyulladások és a felső légúti fertőzések kezelésében is alkalmazzák a mézet. Egy kutatás például kimutatta, hogy a méz hatékonyabbnak bizonyult a köhögés csillapításában gyermekeknél, mint a vény nélkül kapható köhögéscsillapítók. A méz nyugtató hatása és antimikrobiális képessége hozzájárulhat a tünetek enyhítéséhez.
A fogászati egészség területén is vizsgálták a méz hatását. Bizonyos mézek, mint például a manukaméz, képesek lehetnek csökkenteni a fogplakk képződését és a fogínygyulladást okozó baktériumok szaporodását. Ez a hatás a mézben található enzimeknek és bioaktív vegyületeknek köszönhető.
Fontos megjegyezni, hogy a klinikai alkalmazásokhoz általában steril, gyógyászati célra minősített mézeket használnak, amelyek összetétele és tisztasága garantált. A különböző mézfajták eltérő antibakteriális hatékonysággal rendelkezhetnek, ezért a megfelelő méz kiválasztása kulcsfontosságú a terápiás hatás eléréséhez.
A méz alkalmazása sebkezelésben és fertőzések megelőzésében
A méz évszázadok óta elismert gyógyító tulajdonságokkal bír, különösen a sebkezelés és a fertőzések megelőzésének területén. A korábbiakban már érintettük a méz komplex összetételét és antibakteriális mechanizmusait, most pedig ezek gyakorlati alkalmazására fókuszálunk.
A méz antibakteriális hatása révén kitűnő választás lehet kisebb sérülések, horzsolások, vágások és felületes égési sérülések kezelésére. Amikor mézet viszünk fel egy sebre, az egyrészt nedves sebkörnyezetet biztosít, ami elősegíti a sejtek regenerálódását és a gyógyulási folyamatot. Másrészt, a mézben található, már említett antibakteriális komponensek – mint a hidrogén-peroxid, a magas cukortartalom ozmotikus hatása, az alacsony pH, valamint a bioaktív vegyületek – aktívan küzdenek a sebet elfertőző baktériumok ellen, megelőzve ezzel a gyulladást és a szövődményeket.
Különösen hatékony lehet a méz az úgynevezett krónikus sebek, például diabéteszes lábfekélyek vagy felfekvések kezelésében. Ezek a sebek gyakran nehezen gyógyulnak, és hajlamosak a fertőződésre. A méz alkalmazása segíthet csökkenteni a baktériumterhelést, elősegíteni a seb debridementjét (az elhalt szövetek eltávolítását) és javítani a sebágy állapotát. Az orvosi minőségű mézek, amelyeket speciálisan sebkezelésre sterilizálnak és szabványosítanak, egyre elterjedtebbé válnak a klinikai gyakorlatban is.
A méz alkalmazása sebkezelésben nem csupán a fertőzések megelőzését szolgálja, hanem aktívan hozzájárul a sebgyógyulás felgyorsításához és a szövetregeneráció javításához.
A méz antimikrobiális tulajdonságai révén védelmet nyújthat a bőrön keresztül bejutó kórokozókkal szemben is. Enyhe bőrirritációk, pattanások vagy akár kisebb gombás fertőzések esetén is alkalmazható. A méz gyulladáscsökkentő hatása is jelentős, ami tovább fokozza a bőr nyugtatását és regenerálódását.
A méz sebkezelésben történő alkalmazásának egyik előnye a természetessége és a mellékhatások alacsony kockázata, összehasonlítva egyes szintetikus sebkezelő készítményekkel. Fontos azonban megjegyezni, hogy méz alkalmazása előtt, különösen nagyobb vagy mélyebb sebek esetén, mindig javasolt orvos vagy egészségügyi szakember tanácsát kikérni. A megfelelő méz kiválasztása is lényeges; a manukaméz például kiemelkedő antibakteriális hatása miatt gyakran előnyben részesül ilyen esetekben.
A méz külsőleg történő használata során a szűrt, orvosi minőségű méz a legalkalmasabb, mivel ez garantálja a sterilitást és a hatóanyagok optimális koncentrációját. A mézet általában vékony rétegben viszik fel a megtisztított sebre, és kötszerrel fedik le. A gyakori kötéscsere biztosítja a seb tisztaságát és a méz hatékonyságát.
Sebgyógyulás elősegítése mézzel
A méz alkalmazása a sebgyógyítás területén már az ókori civilizációkban is elterjedt volt, és a modern tudomány mára már igazolta ennek hatékonyságát. A méz nem csupán egy természetes kötszer, hanem aktívan elősegíti a szövetek regenerálódását és csökkenti a gyulladásos folyamatokat. Az eddigiekben már említett antibakteriális tulajdonságai révén a méz megakadályozza a seb fertőződését, ami kulcsfontosságú a sikeres gyógyuláshoz.
A méz nedves sebkörnyezetet biztosít, ami elengedhetetlen a sejtek optimális működéséhez és a gyógyulási folyamat felgyorsításához. Ez a nedves közeg segít megelőzni a seb beszáradását és a sebhártya képződését, ami hátráltathatja a gyógyulást. Ezen kívül a méz serkenti az új szövetek növekedését és a kollagénszintézist, ami hozzájárul a seb záródásához és a hegesedés minimalizálásához.
A méz gyulladáscsökkentő hatása is jelentős szerepet játszik a sebgyógyulásban, csökkentve a fájdalmat és a duzzanatot.
A méz alkalmazható különféle típusú sebek kezelésére, beleértve a krónikus fekélyeket, mint például a lábszárfekély vagy a diabéteszes lábfekély. Ezeknél a nehezen gyógyuló sebeknél a méz segíthet csökkenteni a baktériumterhelést, elősegíteni a gyulladás csökkenését és stimulálni a granulációs szövet képződését. Az égési sérülések kezelésében is hatékony, mivel csökkenti a gyulladást, a fájdalmat és elősegíti a bőr regenerálódását, miközben véd a fertőzésektől.
A méz speciális formái, mint például a steril orvosi minőségű méz, kifejezetten sebkezelésre lettek kifejlesztve. Ezek a termékek biztosítják a méz terápiás előnyeit, miközben garantálják a sterilitást és a biztonságos használatot. Az ilyen mézek hatékonysága nagymértékben függ a méz típusától és az abban található aktív vegyületek koncentrációjától, mint például a manukaméz esetében a metilglioxál (MGO).
A méz használata a sebkezelésben nemcsak a fertőzések elleni küzdelemben és a gyógyulás elősegítésében segít, hanem csökkenti a sebészeti beavatkozások szükségességét is bizonyos esetekben. A méz természetes összetevői révén kíméletesebb és kevésbé invazív módszer a sebek kezelésére, mint sok hagyományos orvosi készítmény.
A méz mint természetes antibiotikum-helyettesítő
A méz természetes antimikrobiális tulajdonságai révén értékes alternatívát kínálhat a szintetikus antibiotikumokkal szemben, különösen a gyakori fertőzések és a sebkezelés terén. Míg a hagyományos antibiotikumok gyakran specifikus baktériumokra hatnak, a méz komplex összetétele több mechanizmuson keresztül támadja a kórokozókat, ami csökkentheti a rezisztencia kialakulásának esélyét. Az már ismert, hogy a méz ozmotikus hatása, savassága és a hidrogén-peroxid termelése is hozzájárul antimikrobiális hatékonyságához.
Az újabb kutatások azonban rávilágítottak a mézben található egyéb, nem-peroxidikus antibakteriális komponensek jelentőségére is. Ezek a vegyületek, mint például a manukamézben fellelhető metilglioxál (MGO), önmagukban is képesek jelentős károsodást okozni a baktériumsejtekben, akár még azokra a törzsekre is hatékonyan, amelyek bizonyos mértékig ellenállóak a hidrogén-peroxid hatásával szemben.
Ezen komplex hatásmechanizmusok miatt a méz alkalmazása kiegészítheti vagy helyettesítheti a hagyományos terápiákat bizonyos esetekben. Például a felső légúti fertőzések tüneteinek enyhítésében, köhögés csillapításában a méz hatékonysága jól dokumentált. Különösen a gyermekek esetében, ahol az antibiotikumok használatát óvatosan kell alkalmazni, a méz egy biztonságosabb és hatékonyabb megoldást nyújthat.
A méz tehát nem csupán egy édesítőszer, hanem egy sokoldalú természetes gyógyszer, amely képes felvenni a harcot számos mikroorganizmus ellen, beleértve azokat is, amelyekkel szemben a modern orvostudomány is kihívásokkal néz szembe.
A méz antibakteriális hatékonysága koncentrációfüggő, és a méz típusa is meghatározó tényező. Fontos megkülönböztetni a különböző mézeket, mivel összetételük és ezáltal hatékonyságuk is eltérő lehet. A gyógyászati célra szánt mézek, mint a manukaméz, szigorú minőségellenőrzésen esnek át, hogy biztosítsák standardizált antibakteriális aktivitásukat.
A méz belsőleges használata és egészségügyi előnyei

A méz belsőleges fogyasztása során is érvényesülnek antibakteriális tulajdonságai, különösen az emésztőrendszerben. A méz képes befolyásolni a bélflóra összetételét, előnyben részesítve a jótékony baktériumokat. Ezáltal segíthet a bélrendszeri egyensúly helyreállításában, ami számos egészségügyi probléma megelőzésében és kezelésében játszhat szerepet.
A torokfájás és köhögés enyhítésében is régóta ismert a méz jótékony hatása. A méz bevonó tulajdonsága megnyugtatja az irritált nyálkahártyát, míg antibakteriális komponensei segíthetnek leküzdeni a fertőzést okozó baktériumokat vagy vírusokat. Enyhe fertőtlenítő hatása révén csökkentheti a gyulladást és elősegítheti a gyógyulást.
A méz belsőleges fogyasztása hozzájárulhat a szervezet általános védekezőképességének erősítéséhez, különösen a légúti fertőzésekkel szemben.
A kutatások azt is kimutatták, hogy a méz bizonyos gyomor- és bélrendszeri fertőzések, mint például a Helicobacter pylori fertőzés esetén is kifejthet pozitív hatást. Bár a pontos mechanizmus még kutatás tárgyát képezi, feltételezik, hogy a méz antibakteriális összetevői közvetlenül képesek gátolni e kórokozók szaporodását, vagy segíthetik az immunrendszert a leküzdésükben.
Fontos megjegyezni, hogy a méz belsőleges használata esetén is érvényesek az eddig említett, a méz típusától függő antibakteriális hatások. A különböző mézek eltérő hatékonysággal bírhatnak a bélrendszeri vagy légúti fertőzésekkel szemben. Azonban általánosságban elmondható, hogy a természetes méz fogyasztása jó kiegészítője lehet az egészséges életmódnak és a szervezet védekezőképességének támogatásának.
A méz fogyasztásának előnyei nem merülnek ki pusztán az antibakteriális hatásokban. Gazdag antioxidánsokban, vitaminokban és ásványi anyagokban is, amelyek tovább erősítik a szervezet egészségét. Ez a holisztikus megközelítés teszi a mézet igazán értékes élelmiszerré és gyógyszerré, amelyet már évezredek óta használnak az emberiség. Különösen a gyulladáscsökkentő és immunrendszer-erősítő hatásai emelhetők ki a belsőleges fogyasztás kapcsán.
Immunrendszer erősítése mézzel
A méz antibakteriális tulajdonságai közvetlenül hozzájárulhatnak az immunrendszer erősítéséhez, különösen a szervezet védekezőképességének fokozásával. Bár az eddigiekben a méz direkt antimikrobiális hatásait vizsgáltuk, fontos megérteni, hogy ez a képesség hogyan támogatja általános egészségünket.
A méz fogyasztása révén a szervezetünkbe juttatott jótékony vegyületek, mint például a bioaktív antioxidánsok (flavonoidok, fenolsavak), segíthetnek csökkenteni a szervezetben zajló gyulladásos folyamatokat. A krónikus gyulladás gyengítheti az immunrendszer hatékony működését, így a gyulladáscsökkentő hatás révén a méz hozzájárulhat az immunválasz optimális működéséhez.
Ezen túlmenően, a méz összetételében található prebiotikus jellegű oligoszacharidok is szerepet játszhatnak. Ezek a szénhidrátok táplálékul szolgálnak a bélrendszer jótékony baktériumai számára, elősegítve azok szaporodását. Az egészséges bélflóra kulcsfontosságú az immunrendszer megfelelő működésében, mivel a bélünkben található immunsejtek jelentős része szoros kapcsolatban áll a bélmikrobiommal.
A méz antibakteriális és gyulladáscsökkentő hatásai, valamint a bélflóra egészségének támogatása révén komplex módon járul hozzá az immunrendszer erősítéséhez.
A méz fogyasztása, különösen a hidegebb hónapokban, segíthet megelőzni a felső légúti fertőzéseket. Az enyhe köhögéscsillapító hatása és a torok irritációjának csökkentése révén megkönnyebbülést hozhat, miközben a benne található természetes antimikrobiális komponensek is aktívan részt vesznek a kórokozók elleni küzdelemben. Ezáltal a szervezet kevésbé terhelődik meg a fertőzések leküzdésével, és az immunrendszer hatékonyabban tud más fenyegetésekre reagálni.
Fontos kiemelni, hogy a méz fogyasztása nem helyettesíti a kiegyensúlyozott étrendet és az egészséges életmódot, de kiváló kiegészítője lehet egy olyan megközelítésnek, amely az immunrendszer természetes erősítésére törekszik. Az egészséges méz kiválasztása, amely nem esett át túlzott feldolgozáson, maximalizálja a benne rejlő jótékony hatásokat.
A méz mint természetes köhögéscsillapító és torokfájás csillapító
A méz régóta ismert népi gyógymódként a köhögés és torokfájás enyhítésére, és ezt a hatékonyságát antibakteriális tulajdonságai is alátámasztják. Amikor megfázás vagy légúti fertőzés támad, a méz nemcsak a tünetek csillapításában segít, hanem a háttérben meghúzódó baktériumok leküzdésében is szerepet játszik.
A torok irritációja és a köhögési inger gyakran gyulladásos folyamatokhoz és a nyálkahártya kiszáradásához kapcsolódik. A méz nyugtató bevonatot képez a garatban, csökkentve az ingert és a fájdalmat. Ez a fizikai hatás, párosulva a méz természetes antibakteriális képességeivel, kettős előnyt jelent. A mézben található baktériumellenes komponensek, mint például a hidrogén-peroxid és a bioaktív vegyületek, segíthetnek elpusztítani azokat a kórokozókat, amelyek hozzájárulhatnak a torokfájáshoz és a köhögéshez.
A méz gyulladáscsökkentő és antibakteriális hatása révén egyaránt hozzájárul a felső légúti fertőzések okozta köhögés és torokfájás enyhítéséhez.
Különösen hatékony lehet a méz a baktériumok által okozott fertőzések esetén, amelyek gyakran kísérik a megfázást. Azáltal, hogy gátolja a baktériumok szaporodását és elpusztítja azokat, a méz segíthet megelőzni a fertőzés súlyosbodását, és gyorsíthatja a gyógyulási folyamatot. Ez a hatás különösen fontos lehet gyermekeknél, ahol a gyógyszeres kezelésekkel szemben gyakran előnyben részesítik a természetes alternatívákat.
A méz használata köhögéscsillapítóként rendkívül egyszerű: egy-két evőkanál méz önmagában vagy langyos teával elkeverve fogyasztható. Fontos megjegyezni, hogy a méz nem alkalmas 1 éves kor alatti csecsemők számára a botulizmus kockázata miatt. Felnőtteknél és idősebb gyermekeknél azonban a méz egy biztonságos és hatékony természetes szer a légúti panaszok kezelésére.
A méz alkalmazásának lehetséges mellékhatásai és óvintézkedések
Bár a méz számos előnnyel rendelkezik antibakteriális tulajdonságai révén, mint minden természetes vagy gyógyszeres kezelés esetében, itt is figyelembe kell venni a lehetséges mellékhatásokat és az óvintézkedéseket. Ezek ismerete elengedhetetlen a biztonságos és hatékony alkalmazáshoz.
Az egyik legfontosabb óvintézkedés a csecsemők mézet való etetése. Egyéves kor alatt soha ne adjunk mézet csecsemőknek, mivel fennáll a veszélye a botulizmus nevű, súlyos betegség kialakulásának. Ennek oka, hogy a mézben előfordulhatnak Clostridium botulinum spórák, amelyek a csecsemők éretlen emésztőrendszerében toxinokat termelhetnek. Felnőtteknél és idősebb gyermekeknél ez a kockázat elhanyagolható.
Azok számára, akik allergiásak a méhekre vagy a méhészeti termékekre, a méz fogyasztása vagy külsőleg történő alkalmazása allergiás reakciót válthat ki. Ezek a tünetek enyhétől (bőrkiütés, viszketés) súlyosig (anafilaxiás sokk) terjedhetnek. Ezért, ha valaki gyanítja, hogy allergiás, óvatosan kell elkezdeni a méz használatát, vagy kerülni kell azt.
A méz magas cukortartalma miatt cukorbetegeknek óvatosan kell fogyasztaniuk. Bár a méz szénhidráttartalma természetes eredetű, mégis befolyásolhatja a vércukorszintet. Fontos, hogy a méz fogyasztását beillesszék a napi szénhidrátbevitelükbe, és konzultáljanak kezelőorvosukkal vagy dietetikusukkal.
A méz antibakteriális hatása nem jelenti azt, hogy minden fertőzést képes kezelni, és nem helyettesíti a professzionális orvosi ellátást súlyos vagy krónikus esetekben.
Külsőleg történő alkalmazás esetén, különösen nyílt sebeken, fontos a megfelelő higiénia. A nem megfelelően kezelt vagy tárolt méz kontaminálódhat, ami növelheti a fertőzés kockázatát. A steril orvosi mézek, amelyeket kifejezetten sebkezelésre fejlesztettek ki, általában biztonságosabbak és hatékonyabbak e célra.
Ritkán, de előfordulhatnak emésztési problémák, mint például puffadás vagy hasmenés, különösen nagyobb mennyiségű méz fogyasztása esetén. Ez összefügghet a mézben található fruktánokkal, amelyek egyeseknél emésztési zavart okozhatnak.
Fontos megjegyezni, hogy a méz antibakteriális hatékonysága eltérő lehet a különböző fajtáknál. Míg egyes mézek, mint a manukaméz, kiemelkedő antimikrobiális tulajdonságokkal bírnak, addig másoké mérsékeltebb. Ezért a méz típusának megválasztása az alkalmazás céljától függően fontos lehet.
Botulizmus veszélye csecsemőknél
Bár a méz kimagasló antibakteriális tulajdonságokkal rendelkezik, és számos kórokozóval szemben hatékony, létezik egy specifikus, csecsemőkre vonatkozó kockázat, amelyet mindenképpen figyelembe kell venni. Ez a Clostridium botulinum baktérium spóráinak jelenléte, amely egyes mézfajtákban előfordulhat.
Ezek a spórák általában ártalmatlanok a felnőtt, egészséges emésztőrendszerrel rendelkező egyénekre, mivel a bélflórájuk képes megakadályozni a baktériumok elszaporodását és a toxintermelést. Azonban egy év alatti csecsemők emésztőrendszere még nem teljesen fejlett, és nem rendelkezik a szükséges védekezőképességgel.
A méz fogyasztása egy év alatti csecsemők számára botulizmus kockázatot hordoz magában, mivel a mézben található Clostridium botulinum spórák elszaporodhatnak a fejletlen bélrendszerükben, és veszélyes toxint termelhetnek.
A botulizmus egy súlyos, potenciálisan életveszélyes betegség, amely az idegrendszert támadja meg. Tünetei közé tartozhat a gyengeség, a nyelési nehézség, a bénulás és légzési problémák. Ezért rendkívül fontos, hogy semmilyen formában ne adjunk mézet egy évnél fiatalabb csecsemőknek, sem nyersen, sem feldolgozva, még akkor sem, ha a méz egyébként kiváló antibakteriális tulajdonságokkal rendelkezik. Az egészségügyi szakemberek egységesen ezt az ajánlást teszik.
Allergiás reakciók és a méz fogyasztásának korlátai
Bár a méz számos pozitív tulajdonsággal rendelkezik, fontos tisztában lenni azzal, hogy nem mindenki fogyaszthatja biztonsággal. Az egyik leggyakoribb aggály az allergiás reakciók lehetősége. A méz polleneket és más növényi eredetű anyagokat is tartalmazhat, amelyek allergiás tüneteket válthatnak ki azoknál, akik érzékenyek rájuk. Ezek a tünetek az enyhe viszketéstől és kiütésektől egészen a súlyos, életveszélyes anafilaxiás sokkig terjedhetnek.
Különösen óvatosnak kell lenniük azoknak, akik pollenallergiában szenvednek, hiszen a mézben található virágpor fokozhatja a tüneteiket. Azoknak, akiknek korábban már volt allergiás reakciójuk mézre vagy méhészeti termékekre, teljesen kerülniük kell a mézfogyasztást.
A méz fogyasztása nem ajánlott 1 év alatti csecsemőknek a botulizmus kockázata miatt.
A méz természetes baktériumölő hatása ellenére, tartalmazhat olyan spórákat, amelyek a csecsemők éretlen emésztőrendszerében képesek elszaporodni és veszélyes mérgeket termelni. Ezen felül, a cukorbetegeknek is mértékkel kell fogyasztaniuk a mézet, mivel az magas fruktóz- és glükóztartalma miatt jelentősen befolyásolhatja vércukorszintjüket. Bár természetes édesítőszerként értékes, a szénhidrátbevitel szempontjából hasonlóan kell kezelni, mint a finomított cukrot.
Azok számára, akik nem allergiásak és nincsenek speciális egészségügyi problémáik, a méz mértékletes fogyasztása biztonságos és előnyös lehet. Azonban mindig érdemes kiváló minőségű, megbízható forrásból származó mézet választani, amelynek összetétele ismeretlen tényezőktől mentes.
A jövőbeli kutatási irányok és a méz potenciálja az antimikrobiális terápiában
A méz antibakteriális tulajdonságainak mélyebb megértése és a potenciális alkalmazási területeinek feltárása folyamatos kutatási fókuszt jelent. A jövőbeli kutatások egyik kiemelt területe az egyes mézfajták specifikus bioaktív komponenseinek azonosítása és kvantifikálása. Bár már ismertek kulcsfontosságú tényezők, mint a metilglioxál (MGO) a manukamézben, további vizsgálatok tárhatják fel más mézek egyedi, talán még fel nem fedezett antimikrobiális hatóanyagait.
Egy másik fontos kutatási irány a méz és a modern terápiák kombinált alkalmazásának vizsgálata. Az antibiotikum-rezisztens baktériumok terjedése globális egészségügyi kihívást jelent, és a méz, mint természetes antimikrobiális szer, új stratégiákat kínálhat. A kutatók arra törekszenek, hogy megértsék, hogyan képes a méz szinergiát alkotni bizonyos antibiotikumokkal, növelve azok hatékonyságát, vagy éppen csökkentve a szükséges dózist, ezáltal minimalizálva a mellékhatásokat.
A méz alapú antimikrobiális szerek standardizálása és klinikai validálása is elengedhetetlen a szélesebb körű orvosi alkalmazáshoz. Ez magában foglalja a különböző mézek antibakteriális hatásának pontos mérésére szolgáló módszerek kidolgozását és elfogadását, valamint a hatékonyság és biztonság igazolását célzó, szigorú klinikai vizsgálatok lefolytatását. Különösen a krónikus sebek kezelésében, ahol a fertőzés kockázata magas, a méz potenciálja jelentős.
A méz mint orvosi segédeszköz, különösen sebkezelésben és fertőzésmegelőzésben, komoly lehetőségeket rejt magában a jövő terápiás stratégiáiban.
A kutatások arra is irányulnak, hogy jobban megértsék a méz hatását a baktériumok biofilm képződésére. A biofilm egy olyan, baktériumok által létrehozott védőréteg, amely jelentősen növeli az antibiotikum-rezisztenciát. A méz képes lehet megakadályozni a biofilm kialakulását, vagy lebontani a már meglévőket, ami új utakat nyithat a krónikus fertőzések kezelésében.
Az is vizsgálandó, hogy a különböző mézkoncentrációk és alkalmazási formák (például gélek, kenőcsök, oldatok) hogyan befolyásolják az antibakteriális hatékonyságot és a szövetekkel való kompatibilitást. A cél egy olyan, biztonságos és hatékony mézalapú antimikrobiális terápia kidolgozása, amely kiegészítheti vagy akár helyettesítheti a jelenlegi, néha korlátozott hatékonyságú kezelési módszereket.
Az emberi mikrobiómra gyakorolt hatás vizsgálata is fontos terület. Bár a méz elpusztítja a káros baktériumokat, fontos tudni, hogy nem károsítja-e a jótékony baktériumokat is. Ez az információ kulcsfontosságú a méz belsőleg történő alkalmazásának biztonságosságának megítélésében.